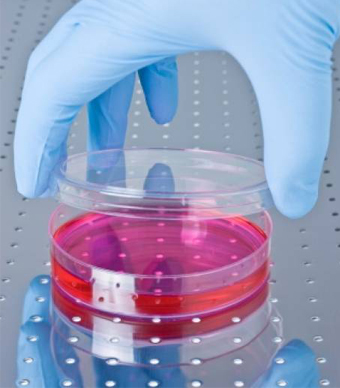

قفزة علمية هائلة في أبحاث الخلايا الجذعية القلبية

 تمت مضاعفة الخلايا الجذعية المأخوذة من نسيج من الأذين الأيمن للقلب في المختبر ثم تم حقنها في جزء تالف من عضلة القلب. وبعد عام واحد، أصبح الجزء التالف أصغر من ذي قبل
وصف العلماء أول نتائج لأبحاث يتم إجراؤها على الخلايا الجذعية التي عادة ما توجد في القلب، بأنها «مذهلة» و«مفحمة». وعلى الرغم من أن تلك النتائج كانت مشجعة للغاية، فإن أبحاث الخلايا الجذعية لا تزال في بدايتها، ولا يزال هناك طريق طويل أمامها قبل أن تتوصل إلى تطوير عقاقير فعالة لمرضى القلب.
خلايا جذعية قلبية
يذكر أن الخلايا الجذعية هي خلايا «خام» يمكن أن تتطور إلى نوع آخر من الخلايا. ويمكن لبعض الخلايا الجذعية، مثل الخلايا الجذعية الجنينية، أن تتحول لخلية عضلة قلب، أو خلية كبد أو أي نوع آخر من الخلايا. وتتميز بعض الخلايا الجذعية الأخرى بقدرات محدودة، ولكن بإمكانها القيام بالعديد من الوظائف الحيوية مثل إنتاج خلايا الدم. وقد أعادت الأبحاث الأولية للخلايا الجذعية الأمل في إعادة إحياء النسيج العضلي الذي يتم تدميره عند الإصابة بالأزمات القلبية أو أي مجهود قلبي آخر.
وقد ركزت معظم الدراسات السابقة لعلاج أمراض القلب بالخلايا الجذعية اهتمامها على الخلايا الجذعية من النخاع، ولا يزال من غير المؤكد ما إذا كانت تلك الخلايا تستطيع بالفعل تحسين وظيفة القلب أم لا.
وفي التجربة الشهيرة المعروفة باسم الخلايا الجذعية لعلاج القلب لدى المرضى الذين يعانون من اعتلال عضلة القلب والمعروفة اختصارا باسم «سكيبيو» SCIPIO، قام الباحثون باختبار الخلايا الجذعية المأخوذة بصورة مباشرة من أنسجة القلب البشري.
وشارك 14 شخصا في تجربة «سكيبيو»، وكانوا جميعا قد نجوا من نوبة قلبية أدت إلى أن البطين الأيسر (الحجرة الرئيسية في القلب لضخ الدم) كان يضخ الدم بشكل سيئ، وقد خضعوا جميعا لجراحة القلب المفتوح وتغيير الشرايين. وحصل الباحثون على الخلايا الجذعية من نسيج صغير تم استئصاله أثناء عملية تغيير الشرايين، ثم قاموا بزرعها في المختبر وحقنها في القلب بعد ذلك بأربعة أشهر.
حقن الخلايا
وفي تجربة «سكيبيو»، تمت مضاعفة الخلايا الجذعية المأخوذة من نسيج من الأذين الأيمن للقلب في المختبر ثم تم حقنها في جزء تالف من عضلة القلب. وبعد عام واحد، أصبح الجزء التالف أصغر من ذي قبل. وكان الهدف الرئيسي من تجربة «سكيبيو» هو تحديد ما إذا كان استخدام الخلايا الجذعية المأخوذة من القلب آمنا أم لا. وقد أحدثت بعض أنواع الخلايا الجذعية التي تم استخدامها في دراسات سابقة مخاوف بشأن حدوث اضطرابات بدقات القلب، بينما لم يواجه أي شخص مشكلات بالنسبة لدقات القلب أثناء تجربة «سكيبيو».
وكان الشيء المذهل في الأمر هو أن قدرة البطين على ضخ الدم - وهو مقياس يطلق عليه الأطباء اسم «نسبة الانقباض» - قد ارتفعت من 30 في المائة إلى 39 في المائة تقريبا بعد أربعة أشهر، وإلى 42 في المائة بعد عام بالنسبة لمستقبلي الخلايا الجذعية (تتراوح نسبة الانقباض الطبيعية بين 55 في المائة و70 في المائة).
وعلاوة على ذلك، أظهر الفحص بالرنين المغناطيسي انخفاض حجم الندبة التي يخلفها تلف عضلة القلب نتيجة التعرض لأزمات قلبية بالنسبة للأشخاص الذين حصلوا على خلايا جذعية مأخوذة من القلب. وعلى النقيض من ذلك، لم يلاحظ الباحثون حدوث تغييرات مماثلة بين 7 أشخاص يمرون بالظروف الصحية نفسها، ولكنهم لم يحصلوا على خلايا جذعية. (الموقع الإلكتروني لمجلة «لانسيت»، 14 نوفمبر/ تشرين الثاني 2011).
ويقول الدكتور ريتشارد لي، نائب رئيس تحرير «رسالة هارفارد للقلب»: «تعد زيادة الانقباض بنسبة 12 في المائة شيئا رائعا، حيث لم تتجاوز النسبة ما يتراوح بين 4 في المائة و5 في المائة في الدراسات التي اعتمدت على خلايا جذعية مأخوذة من نخاع العظام، ولكن تعتبر تجربة (سكيبيو) خطوة صغيرة للأمام، فغالبا لا تصمد النتائج الأولية في التجارب المحكمة على نطاق أوسع».
وتطرح نتائج «سكيبيو» تساؤلا عما إذا كانت القوة المتجددة للخلايا الجذعية المشتقة من عضلة القلب أكبر من تلك المشتقة من نخاع العظام أم لا، حيث لاحظ الباحثون أثناء دراسة لزيادة نسبة الانقباض باستخدام خلايا جذعية مشتقة من نخاع العظام أنه لا يوجد فارق بين أولئك الذين أصيبوا بنوبات قلبية وحصلوا على الخلايا الجذعية والآخرين الذين لم يحصلوا عليها. (المجلة الطبية الأميركية، 16 نوفمبر/ تشرين الثاني 2011).
آمال واعدة
ومع ذلك، يمكن أن تدفع تلك النتائج السلبية الأبحاث إلى الأمام، حيث حصل الأشخاص في الدراسات التي نشرتها «الجمعية الطبية الأميركية» على الخلايا الجذعية خلال فترة تتراوح بين أسبوعين وثلاثة أسابيع عقب خضوعهم للجراحة في الأوعية الدموية، وهو ما يعزز فرضية البحث السابق بأن استخدام الخلايا الجذعية المشتقة من نخاع العظام خلال فترة تتراوح بين أربعة وثمانية أيام بعد الإصابة بأزمة قلبية هو الأفضل.
ولكن السؤال الآن هو: لماذا لا يتم القيام بذلك عقب الإصابة مباشرة؟ ويشير البحث السابق إلى أن «البيئة الدقيقة» لنسيج القلب تعجز عن مساعدة الخلايا الجذعية على الاستقرار بعد الإصابة بأزمة قلبية مباشرة.
وبما أن تجربة «سكيبيو» تعد الأولى في استخدام الخلايا الجذعية المشتقة من القلب، يظل التوقيت الأفضل للعلاج بالخلايا الجذعية المشتقة من القلب سؤالا لم يحسم بعد.
وللرد على ذلك السؤال وغيره من الأسئلة، ما زالت هناك تجارب سريرية مستمرة لاختبار العلاج بالخلايا الجذعية لأمراض القلب. (بإمكانك رؤية القائمة على موقع health.harvard.edu/179).
«والأمل ينبع على نحو سرمدي في الصدر البشري»، على حد قول الشاعر ألكسندر بوب، ولكن الأبحاث وحدها هي التي ستكشف ما إذا كان بإمكان الخلايا الجذعية شفاء القلوب المريضة أم لا.
تمت مضاعفة الخلايا الجذعية المأخوذة من نسيج من الأذين الأيمن للقلب في المختبر ثم تم حقنها في جزء تالف من عضلة القلب. وبعد عام واحد، أصبح الجزء التالف أصغر من ذي قبل
وصف العلماء أول نتائج لأبحاث يتم إجراؤها على الخلايا الجذعية التي عادة ما توجد في القلب، بأنها «مذهلة» و«مفحمة». وعلى الرغم من أن تلك النتائج كانت مشجعة للغاية، فإن أبحاث الخلايا الجذعية لا تزال في بدايتها، ولا يزال هناك طريق طويل أمامها قبل أن تتوصل إلى تطوير عقاقير فعالة لمرضى القلب.
خلايا جذعية قلبية
يذكر أن الخلايا الجذعية هي خلايا «خام» يمكن أن تتطور إلى نوع آخر من الخلايا. ويمكن لبعض الخلايا الجذعية، مثل الخلايا الجذعية الجنينية، أن تتحول لخلية عضلة قلب، أو خلية كبد أو أي نوع آخر من الخلايا. وتتميز بعض الخلايا الجذعية الأخرى بقدرات محدودة، ولكن بإمكانها القيام بالعديد من الوظائف الحيوية مثل إنتاج خلايا الدم. وقد أعادت الأبحاث الأولية للخلايا الجذعية الأمل في إعادة إحياء النسيج العضلي الذي يتم تدميره عند الإصابة بالأزمات القلبية أو أي مجهود قلبي آخر.
وقد ركزت معظم الدراسات السابقة لعلاج أمراض القلب بالخلايا الجذعية اهتمامها على الخلايا الجذعية من النخاع، ولا يزال من غير المؤكد ما إذا كانت تلك الخلايا تستطيع بالفعل تحسين وظيفة القلب أم لا.
وفي التجربة الشهيرة المعروفة باسم الخلايا الجذعية لعلاج القلب لدى المرضى الذين يعانون من اعتلال عضلة القلب والمعروفة اختصارا باسم «سكيبيو» SCIPIO، قام الباحثون باختبار الخلايا الجذعية المأخوذة بصورة مباشرة من أنسجة القلب البشري.
وشارك 14 شخصا في تجربة «سكيبيو»، وكانوا جميعا قد نجوا من نوبة قلبية أدت إلى أن البطين الأيسر (الحجرة الرئيسية في القلب لضخ الدم) كان يضخ الدم بشكل سيئ، وقد خضعوا جميعا لجراحة القلب المفتوح وتغيير الشرايين. وحصل الباحثون على الخلايا الجذعية من نسيج صغير تم استئصاله أثناء عملية تغيير الشرايين، ثم قاموا بزرعها في المختبر وحقنها في القلب بعد ذلك بأربعة أشهر.
حقن الخلايا
وفي تجربة «سكيبيو»، تمت مضاعفة الخلايا الجذعية المأخوذة من نسيج من الأذين الأيمن للقلب في المختبر ثم تم حقنها في جزء تالف من عضلة القلب. وبعد عام واحد، أصبح الجزء التالف أصغر من ذي قبل. وكان الهدف الرئيسي من تجربة «سكيبيو» هو تحديد ما إذا كان استخدام الخلايا الجذعية المأخوذة من القلب آمنا أم لا. وقد أحدثت بعض أنواع الخلايا الجذعية التي تم استخدامها في دراسات سابقة مخاوف بشأن حدوث اضطرابات بدقات القلب، بينما لم يواجه أي شخص مشكلات بالنسبة لدقات القلب أثناء تجربة «سكيبيو».
وكان الشيء المذهل في الأمر هو أن قدرة البطين على ضخ الدم - وهو مقياس يطلق عليه الأطباء اسم «نسبة الانقباض» - قد ارتفعت من 30 في المائة إلى 39 في المائة تقريبا بعد أربعة أشهر، وإلى 42 في المائة بعد عام بالنسبة لمستقبلي الخلايا الجذعية (تتراوح نسبة الانقباض الطبيعية بين 55 في المائة و70 في المائة).
وعلاوة على ذلك، أظهر الفحص بالرنين المغناطيسي انخفاض حجم الندبة التي يخلفها تلف عضلة القلب نتيجة التعرض لأزمات قلبية بالنسبة للأشخاص الذين حصلوا على خلايا جذعية مأخوذة من القلب. وعلى النقيض من ذلك، لم يلاحظ الباحثون حدوث تغييرات مماثلة بين 7 أشخاص يمرون بالظروف الصحية نفسها، ولكنهم لم يحصلوا على خلايا جذعية. (الموقع الإلكتروني لمجلة «لانسيت»، 14 نوفمبر/ تشرين الثاني 2011).
ويقول الدكتور ريتشارد لي، نائب رئيس تحرير «رسالة هارفارد للقلب»: «تعد زيادة الانقباض بنسبة 12 في المائة شيئا رائعا، حيث لم تتجاوز النسبة ما يتراوح بين 4 في المائة و5 في المائة في الدراسات التي اعتمدت على خلايا جذعية مأخوذة من نخاع العظام، ولكن تعتبر تجربة (سكيبيو) خطوة صغيرة للأمام، فغالبا لا تصمد النتائج الأولية في التجارب المحكمة على نطاق أوسع».
وتطرح نتائج «سكيبيو» تساؤلا عما إذا كانت القوة المتجددة للخلايا الجذعية المشتقة من عضلة القلب أكبر من تلك المشتقة من نخاع العظام أم لا، حيث لاحظ الباحثون أثناء دراسة لزيادة نسبة الانقباض باستخدام خلايا جذعية مشتقة من نخاع العظام أنه لا يوجد فارق بين أولئك الذين أصيبوا بنوبات قلبية وحصلوا على الخلايا الجذعية والآخرين الذين لم يحصلوا عليها. (المجلة الطبية الأميركية، 16 نوفمبر/ تشرين الثاني 2011).
آمال واعدة
ومع ذلك، يمكن أن تدفع تلك النتائج السلبية الأبحاث إلى الأمام، حيث حصل الأشخاص في الدراسات التي نشرتها «الجمعية الطبية الأميركية» على الخلايا الجذعية خلال فترة تتراوح بين أسبوعين وثلاثة أسابيع عقب خضوعهم للجراحة في الأوعية الدموية، وهو ما يعزز فرضية البحث السابق بأن استخدام الخلايا الجذعية المشتقة من نخاع العظام خلال فترة تتراوح بين أربعة وثمانية أيام بعد الإصابة بأزمة قلبية هو الأفضل.
ولكن السؤال الآن هو: لماذا لا يتم القيام بذلك عقب الإصابة مباشرة؟ ويشير البحث السابق إلى أن «البيئة الدقيقة» لنسيج القلب تعجز عن مساعدة الخلايا الجذعية على الاستقرار بعد الإصابة بأزمة قلبية مباشرة.
وبما أن تجربة «سكيبيو» تعد الأولى في استخدام الخلايا الجذعية المشتقة من القلب، يظل التوقيت الأفضل للعلاج بالخلايا الجذعية المشتقة من القلب سؤالا لم يحسم بعد.
وللرد على ذلك السؤال وغيره من الأسئلة، ما زالت هناك تجارب سريرية مستمرة لاختبار العلاج بالخلايا الجذعية لأمراض القلب. (بإمكانك رؤية القائمة على موقع health.harvard.edu/179).
«والأمل ينبع على نحو سرمدي في الصدر البشري»، على حد قول الشاعر ألكسندر بوب، ولكن الأبحاث وحدها هي التي ستكشف ما إذا كان بإمكان الخلايا الجذعية شفاء القلوب المريضة أم لا.
صفحة جديدة 2
بإمكانكم
الاتصال بالدكتور انس عبد
الرحمن أخصائي زراعة الأسنان وتركيب أبتسامة هوليود
عبر الواتساب
للأستفسار حول علاج الأسنان في مركز
أسنانك الدولي في اسطنبول
أنقر
هنا ليتم الاتصال المباشر مع الدكتور انس عبد الرحمن أخصائي زراعة وتركيب اسنان
أو إنسخ رقم الموبايل
00905355709310
للأتصال به عبر الموبايل أو الأيمو
كما بإمكانكم الأشتراك في قناة الدكتور أنس
عبد الرحمن ليصلكم كل شي جديد

تمت مضاعفة الخلايا الجذعية المأخوذة من نسيج من الأذين الأيمن للقلب في المختبر ثم تم حقنها في جزء تالف من عضلة القلب. وبعد عام واحد، أصبح الجزء التالف أصغر من ذي قبل
تمت مضاعفة الخلايا الجذعية المأخوذة من نسيج من الأذين الأيمن للقلب في المختبر ثم تم حقنها في جزء تالف من عضلة القلب. وبعد عام واحد، أصبح الجزء التالف أصغر من ذي قبل تعليمات المشاركة
تعليمات المشاركة
